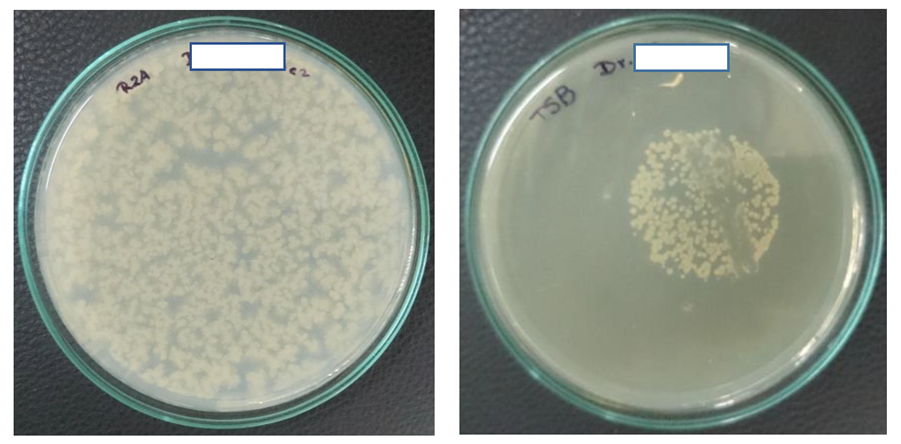
Ijerph 17 02348 g001

Dental Unit Waterlines in Quito and Caracas Contaminated with Nontuberculous Mycobacteria: A Potential Health Risk in Dental Practice
Abstract
1. Introduction
2. Materials and Methods
2.1. Study Design
2.2. Sampling of the Waterlines from the Dental Unit and the Mains
2.3. Bacteriological Analysis of the Water Samples
2.4. Survey on Disinfection Practices
3. Results
3.1. Water Quality in Quito
3.2. Water Quality in Caracas
3.3. Comparison of Water Quality in DUWLs in Caracas and Quito
3.4. Disinfection Practices of DUWLs in Quito and Caracas
4. Discussion
4.1. General Microbiological Quality of Water in the DUWLs
4.2. Nontuberculous Mycobacteria in DUWLs
5. Conclusions
6. Limitations of This Study
Ethics Approval and Consent to Participate
Author Contributions
Funding
Acknowledgments
Conflicts of Interest
Abbreviations
| DUWL | dental unit waterline |
| HPC | heterotrophic plate count |
| CFU/mL | colony-forming units per milliliter |
| NTM | nontuberculous mycobacteria |
| PRA technique | PCR-restriction enzyme analysis |
| ADA | American Dental Association |
| CDC | Centers for Disease Control and Prevention |
References
- Barbot, V.; Robert, A.; Rodier, M.H.; Imbert, C. Update on infectious risks associated with dental unit waterlines. FEMS Immunol. Med. Microbiol. 2012, 65, 196–204. [Google Scholar] [CrossRef] [PubMed]
- Ricci, M.L.; Fontana, S.; Pinci, F.; Fiumana, E.; Pedna, M.F.; Farolfi, P.; Sabattini, M.A.; Scaturro, M. Pneumonia associated with a dental unit waterline. Lancet 2012, 379, 684. [Google Scholar] [CrossRef]
- Leoni, E.; Dallolio, L.; Stagni, F.; Sanna, T.; D’Alessandro, G.; Piana, G. Impact of a risk management plan on Legionella contamination of dental unit water. Int. J. Environ. Res. Public Health 2015, 12, 2344–2358. [Google Scholar] [CrossRef]
- Atlas, R.M.; Williams, J.F.; Huntington, M.K. Legionella contamination of dental-unit waters. Appl. Environ. Microbiol. 1995, 61, 1208–1213. [Google Scholar] [CrossRef]
- Spagnolo, A.M.; Sartini, M.; Cave, D.D.; Casini, B.; Tuvo, B.; Cristina, M.L. Evaluation of Microbiological and Free-Living Protozoa Contamination in Dental Unit Waterlines. Int. J. Environ. Res. Public Health 2019, 16, 2648. [Google Scholar] [CrossRef]
- Laheij, A.M.G.A.; Kistler, J.O.; Belibasakis, G.N.; Välimaa, H.; de Soet, J.J. European Oral Microbiology Workshop (EOMW) 2011. Healthcare-associated viral and bacterial infections in dentistry. J. Oral Microbiol. 2012, 4, 17659. [Google Scholar] [CrossRef]
- Centers for Disease Control and Prevention. Recommended infection control practices for dentistry, 1993. MMWR 1993, 42, 1–12. [Google Scholar]
- Kohn, W.G.; Collins, A.S.; Cleveland, J.L.; Harte, J.A.; Eklund, K.J.; Malvitz, D.M.; Centers for Disease Control and Prevention (CDC). Guidelines for infection control in dental health-care settings—2003. MMWR Recomm. Rep. 2003, 52, 1–61. [Google Scholar]
- American Dental Association. Oral Health Topics. Dental Unit Waterlines. Available online: https://www.ada.org/en/member-center/oral-health-topics/dental-unit-waterlines (accessed on 12 May 2019).
- Shearer, B.G. Biofilm and the dental office. JADA 1996, 127, 181–189. [Google Scholar] [CrossRef] [PubMed]
- The 2018 Edition of the Drinking Water Standards and Health Advisories Office of Water. Environmental Protection Agency Washington, DC. Available online: https://www.epa.gov/sites/production/files/2018-03/documents/dwtable2018.pdf (accessed on 1 October 2019).
- Schulze-Röbbecke, R.; Feldmann, C.; Fischeder, R.; Janning, B.; Exner, M.; Wahl, G. Dental units: An environmental study of sources of potentially pathogenic mycobacteria. Tuber Lung Dis. 1995, 76, 318–323. [Google Scholar] [CrossRef]
- Porteous, N.B.; Redding, S.W.; Jorgensen, J.H. Isolation of non-tuberculosis mycobacteria in treated dental unit waterlines. Oral Surg. Oral Med. Oral Pathol. Oral Radiol. Endod. 2004, 98, 40–44. [Google Scholar] [CrossRef] [PubMed]
- Hatzenbuehler, L.A.; Tobin-D’Angelo, M.; Drenzek, C.; Peralta, G.; Cranmer, L.C.; Andersonn, E.J.; Milla, S.S.; Abramowicz, S.; Yi, J.; Hilinski, J.; et al. Pediatric Dental Clinic-Associated Outbreak of Mycobacterium abscessus Infection. J. Pediatric. Infect. Dis. Soc. 2017, 6, e116–e122. [Google Scholar] [CrossRef] [PubMed]
- Singh, J.; O’Donnell, K.; Ashouri, N.; Singh, J.; O’Donnell, K.; Ashouri, N.; Adler-Shohet, F.C.; Nieves, D.; Tran, M.T.; Arrieta, A.; et al. Outbreak of Invasive Nontuberculous Mycobacterium (NTM) Infections Associated With a Pediatric Dental Practice. Open Forum Infect. Dis. 2018, 5 (Suppl. S1), S29. [Google Scholar] [CrossRef]
- Pérez-Alfonzo, R.; Poleo, L.E.; Ruiz, A.; Meneses Rodriguez, P.L.; Kanee, C.E.; Carera Martinez, C.; Rivero-Oliver, I.A.; Da Mata Jardin, O.J.; Rodriguez Castillo, B.A.; de Waard, J.H. An odontogenic cutaneous sinus tract due to nontuberculous mycobacteria (NTM) infection; a report of three cases. BMC Infect. Dis. 2020, in press. [Google Scholar]
- Rice, E.W.; Rich, W.K.; Johnson, C.H.; Lye, D.J. The role of flushing dental water lines for the removal of microbial contaminants. Public Health Rep. 2006, 121, 270–274. [Google Scholar] [CrossRef]
- Iivanainen, E.; Northrup, J.; Arbeit, R.D.; Ristola, M.; Katila, M.L.; von Reyn, C.F. Isolation of mycobacteria from indoor swimming pools in Finland. APMIS 1999, 107, 193–200. [Google Scholar] [CrossRef]
- APHA. Standards Methods for the Examination of Water and Wastewater, 20th ed.; American Public Health Association: Washington, DC, USA, 1998. [Google Scholar]
- Neumann, M.; Schulze-Röbbecke, R.; Hagenau, C. Comparision of methods for isolation of mycobacteria from water. Appl. Environ. Microbiol. 1997, 63, 547–552. [Google Scholar] [CrossRef]
- Chang, C.L.; Park, T.S.; Oh, S.H.; Kim, H.H.; Lee, E.Y.; Son, H.C.; Kim, C.M. Reduction of contamination of mycobacterial growth indicator tubes with a modified antimicrobial combination. J. Clin. Microbiol. 2002, 40, 3845–3847. [Google Scholar] [CrossRef]
- Telenti, A.; Marchesi, F.; Balz, M.; Bally, F.; Böttger, E.C.; Bodmer, T. Rapid identification of mycobacteria to the species level by polymerase chain reaction and restriction enzyme analysis. J. Clin. Microbiol. 1993, 31, 175–178. [Google Scholar] [CrossRef]
- De Oliveira, A.; Pariz Maluta, R.P.; Stella, A.E.; Rigobelo, E.C.; Marin, J.M.; de Ávila, F.A. Isolation of Pseudomonas aeruginosa strains from dental office environments and units in Barretos, state of São Paulo, Brazil, and analysis of their susceptibility to antimicrobial drugs. Braz. J. Microbiol. 2008, 39, 579–584. [Google Scholar] [CrossRef]
- Souza-Gugelmin, M.C.; Lima, C.D.; Lima, S.N.; Mian, H.; Ito, I.Y. Microbial contamination in dental unit waterlines. Braz. Dent. J. 2003, 14, 55–57. [Google Scholar] [CrossRef] [PubMed][Green Version]
- Damasceno, J.L.; Dos Santos, R.A.; Barbosa, A.H.; Casemiro, L.A.; Pires, R.H.; Martins, C.H.G. Risk of Fungal Infection to Dental Patients. Sci. World J. 2017, 2982478. [Google Scholar] [CrossRef] [PubMed]
- Arvand, M.; Hack, A. Microbial contamination of dental unit waterlines in dental practices in Hesse, Germany: A cross-sectional study. Eur. J. Microbiol. Immunol. 2013, 3, 49–52. [Google Scholar] [CrossRef]
- Lizzadro, J.; Mazzotta, M.; Girolamini, L.; Dormi, A.; Pellati, T.; Cristino, S. Comparison between Two Types of Dental Unit Waterlines: How Evaluation of Microbiological Contamination Can Support Risk Containment. Int. J. Environ. Res. Public Health 2019, 16, 328. [Google Scholar] [CrossRef] [PubMed]
- The Organization for Safety, Asepsis and Prevention (OSAP). Dental Unit Waterlines: Questions. Available online: https://www.osap.org/page/Issues_DUWL_1 (accessed on 22 February 2020).
- Walker, J.T.; Bradshaw, D.J.; Bennett, A.M.; Fulford, M.R.; Martin, M.V.; Marsh, P.D. Microbial biofilm formation and contamination of dental-unit water systems in general dental practice. Appl. Environ. Microbiol. 2000, 66, 3363–3367. [Google Scholar] [CrossRef]
- Rutala, W.A.; Weber, D.J.; The Healthcare Infection Control Practices Advisory Committee (HICPAC). Guideline for Disinfection and Sterilization in Healthcare Facilities, 2008 Update: May 2019. Available online: https://www.cdc.gov/infectioncontrol/guidelines/disinfection/ (accessed on 22 February 2020).
- Cortesia, C.; Lopez, G.J.; de Waard, J.H.; Takiff, H.E. The use of quaternary ammonium disinfectants selects for persisters at high frequency from some species of non-tuberculous mycobacteria and may be associated with outbreaks of soft tissue infections. J. Antimicrob. Chemother. 2010, 65, 2574–2581. [Google Scholar] [CrossRef]
- Bello, T.; Rivera-Olivero, I.A.; de Waard, J.H. Inactivation of mycobacteria by disinfectants with a tuberculocidal label. Enferm. Infecct. Microbiol. Clin. 2006, 24, 319–321. [Google Scholar] [CrossRef]
- Bello-Gonzalez, T.; Rosales-Pantoja, P.; Acosta-Gio, A.E.; de Waard, J.H. Instrument processing with lauryl dimethyl benzyl ammonium bromide: A challenge for patient safety. Am. J. Infect. Control 2008, 36, 598–601. [Google Scholar] [CrossRef]
- Mills, S.E. The dental unit waterline controversy: Defusing the myths, defining the solutions. J. Am. Dent. Assoc. 2000, 131, 1427–1444. [Google Scholar] [CrossRef]
- Volgenant, C.M.C.; de Soet, J.J. Cross-transmission in the Dental Office: Does This Make You Ill? Curr. Oral Health Rep. 2018, 5, 221–228. [Google Scholar] [CrossRef]
- Dean, G.S.; Rhodes, S.G.; Coad, M.; Whelan, A.O.; Cockle, P.J.; Clifford, D.J.; Hewinson, R.G.; Vordermeier, H.M. Minimum infective dose of Mycobacterium bovis in cattle. Infect. Immun. 2005, 73, 6467–6471. [Google Scholar] [CrossRef] [PubMed][Green Version]
- Saini, D.; Hopkins, G.W.; Seay, S.A.; Chen, C.J.; Perley, C.C.; Click, E.M.; Frothingham, R. Ultra-low dose of Mycobacterium tuberculosis aerosol creates partial infection in mice. Tuberculosis 2012, 92, 160–165. [Google Scholar] [CrossRef]
- Rivera-Olivero, I.; Guevara, A.; Escalona, A.; Oliver, M.; Pérez-Alfonzo, R.; Piquero, J.; Zerpa, O.; de Waard, J.H. Soft-tissue infections due to non-tuberculous mycobacteria following mesotherapy. What is the price of beauty? Enferm. Infecct. Microbiol. Clin. 2006, 24, 302–306. [Google Scholar] [CrossRef]
- Murray, A.L.; Kumpel, E.; Peletz, R.; Khush, R.S.; Lantagne, D.S. The effect of sodium thiosulfate dechlorination on fecal indicator bacteria enumeration: Laboratory and field data. J. Water Health 2018, 70–77. [Google Scholar] [CrossRef] [PubMed]
- Ahammed, M.M. Effect of holding time and temperature on bacterial counts. Indian J. Environ. Health 2003, 45, 209–212. [Google Scholar] [PubMed]
- Selvakumar, A.; Borst, M.; Boner, M.; Mallon, P. Effects of sample holding time on concentrations of microorganisms in water samples. Water Environ. Res. 2004, 76, 67–72. [Google Scholar] [CrossRef]
| HPC >500 CFU/mL Main/DUWL | Presence of Coliforms ** % Main/DUWL | Presence of P. aeruginosa % Main/DUWL | Presence of Mycobacteria % Main/DUWL | |||||
|---|---|---|---|---|---|---|---|---|
| Quito | 0% | 69% | 0% | 14% | ND * | ND * | 0% | 3% |
| Caracas | 64% | 84% | 21% | 23% | 29% | 51% | 36% | 56% |
© 2020 by the authors. Licensee MDPI, Basel, Switzerland. This article is an open access article distributed under the terms and conditions of the Creative Commons Attribution (CC BY) license (http://creativecommons.org/licenses/by/4.0/).
Share and Cite
Castellano Realpe, O.J.; Gutiérrez, J.C.; Sierra, D.A.; Pazmiño Martínez, L.A.; Prado Palacios, Y.Y.; Echeverría, G.; de Waard, J.H. Dental Unit Waterlines in Quito and Caracas Contaminated with Nontuberculous Mycobacteria: A Potential Health Risk in Dental Practice. Int. J. Environ. Res. Public Health 2020, 17, 2348. https://doi.org/10.3390/ijerph17072348
Castellano Realpe OJ, Gutiérrez JC, Sierra DA, Pazmiño Martínez LA, Prado Palacios YY, Echeverría G, de Waard JH. Dental Unit Waterlines in Quito and Caracas Contaminated with Nontuberculous Mycobacteria: A Potential Health Risk in Dental Practice. International Journal of Environmental Research and Public Health. 2020; 17(7):2348. https://doi.org/10.3390/ijerph17072348
Chicago/Turabian StyleCastellano Realpe, Orlando J., Johanna C. Gutiérrez, Deisy A. Sierra, Lourdes A. Pazmiño Martínez, Yrneh Y. Prado Palacios, Gustavo Echeverría, and Jacobus H. de Waard. 2020. "Dental Unit Waterlines in Quito and Caracas Contaminated with Nontuberculous Mycobacteria: A Potential Health Risk in Dental Practice" International Journal of Environmental Research and Public Health 17, no. 7: 2348. https://doi.org/10.3390/ijerph17072348
APA StyleCastellano Realpe, O. J., Gutiérrez, J. C., Sierra, D. A., Pazmiño Martínez, L. A., Prado Palacios, Y. Y., Echeverría, G., & de Waard, J. H. (2020). Dental Unit Waterlines in Quito and Caracas Contaminated with Nontuberculous Mycobacteria: A Potential Health Risk in Dental Practice. International Journal of Environmental Research and Public Health, 17(7), 2348. https://doi.org/10.3390/ijerph17072348

